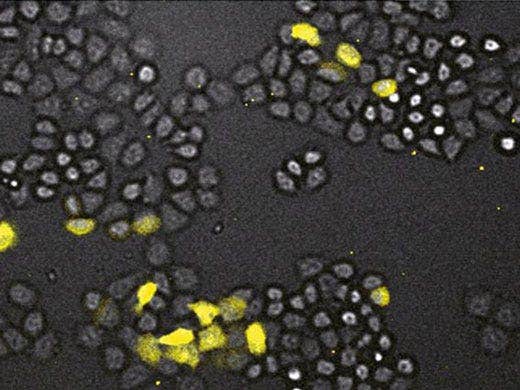
GL3 루시페레이스를 이용한 Hela 세포

LV200
고배율에서의 감광성 세포 및 발광 탐침의 상세한 연구를 지원하는 LV200 생물발광 이미지화 시스템의 기본 온도 제어, 습도 및 가스 흐름은 오래 지속되는 관찰 기간 동안 배양되는 세포와 조직 슬라이스를 보호합니다. 시스템의 고유한 광학 설계는 고배율 생물발광 이미지화를 지원하며 완전 차광 인클로저는 샘플과 광학 장치를 외부 빛으로부터 보호합니다.
고감도를 제공하는 고급 광학 설계
일반적인 발광 현미경 시스템보다 높은 해상도 제공
다양한 배율 옵션 제공
* 이 제품은 단종되었으며 직접적인 대체 제품은 없습니다.

개요

라이브셀 이미징의 비약적 발전
LV200은 장시간의 세포 생물 발광을 관찰하기 위해 신중하게 설계되었습니다. 완전히 새로운 광학설계로 감도가 획기적으로 향상되었으며, 고배율에서 감광성 세포 및 발광 프로브에 대한 자세한 연구가 가능해졌습니다. 온도 제어, 습도 및 가스 흐름을 위한 내장 시스템은 관찰 중에 배양된 세포 또는 조직 슬라이스를 건강한 상태로 유지할 수 있게 해주며, 고유한 광밀폐 엔클로저는 외부 빛으로부터 표본과 광학 장치를 보호합니다.
세포 친화적 이미징
발광은 시료 내에서 발생하며, 세포에 독성 영향을 주지 않습니다. 염려할 만한 배경 노이즈나 자가 형광 또한 없습니다. 따라서 발광은 라이브 셀 이미징에 적합한 빛입니다.
고급 생물 발광 현미경
발광은 배경 방출, 광독성 및 광표백이 없어서 신호-노이즈 비율이 더 개선되는 등 형광물질보다 여러 가지 잠재적 이점을 가지고 있어서 라이브 셀 시스템의 장기적 변화를 정량적으로 추적하는 데 이상적입니다. 발광에 대한 관찰은 이전까지 많은 기술적 난제들에 의해 지연되어 왔습니다. Olympus는 LUMINOVIEW LV200을 통해 이러한 난제들을 극복하고 상용 시스템에서 최초로 생물 발광 이미징의 힘을 활용하는 발광 현미경 시스템을 성공적으로 개발했습니다.
형광 한계의 극복
형광 현미경 및 관련 기술에는 다양한 장점들이 있지만 여러 가지 한계도 있습니다. 생물 발광 이미징은 이러한 한계를 극복할 수 있는 잠재력을 가지고 있습니다. 새로운 Olympus LV200의 독특한 광학 설계는 형광과 생물 발광의 장점을 결합하여 밝은 고해상도 이미지를 촬영할 수 있는 시스템을 제공합니다.

형광
형광 방출은 수명이 짧고 밝은 경향이 있기 때문에 여기를 위해서는 특정 주파수의 빛을 필요로 합니다. 결과적으로 이러한 조명은 이미징 시 필요한데, 이는 광학 시스템이 하나의 파장에서 강하고 완벽하게 제어 가능한 빛을 공급하고 다른 파장에 방출된 빛을 사용자의 눈이나 카메라에 투사할 수 있어야 함을 의미합니다. 이러한 상대적으로 복잡한 광학 조건에도 불구하고 형광 기술은 번성했으며, 다양한 연구 분야에서 획기적인 발견을 가능하게 하고 있습니다.
생물 발광 이미징
발광 방출은 수명이 다양하고 매우 희미한 경우가 많지만, 배경이나 형광이 없기 때문에 높은 신호-노이즈(S/N) 비로 측정할 수 있습니다. 따라서 전체 동물 이미징 또는 화합물 라이브러리의 다양한 화합물을 포함하는 표본 등 자가 형광이 강한 경우에 응용하기가 이상적입니다. 체내 이미징 시스템과 마이크로 플레이트 발광 판독기는 이러한 분야에서 큰 성공을 거두었습니다.
표백/독성 없는 높은 신호-노이즈 비율
생체 발광 이미징은 표백 및 광독성 효과가 없는 높은 신호-노이즈 비율을 결합하므로 형광 이미징에 비해 큰 장점을 지닙니다. 게다가 방출은 신진대사를 통해서만 가능하기 때문에 생존 중인 세포만이 발광 신호를 방출합니다. 그 결과, 생물 발광 측정은 민감한 라이브 셀에 이상적이며, 절대적이고 직접적으로 정량적입니다. 이러한 이점은 이제 더이상 매크로 이미징 및 대량 측정에 국한되지 않으며, 이제 고해상도 현미경에도 적용 가능합니다.
고품질 이미지
Olympus가 개발한 LV200 LUMINOVIEW 생물 발광 이미징 시스템은 특수 광자 검출기가 아닌 표준 CCD를 사용하여 놀랍도록 상세한 이미지를 제공합니다. 이를 위해 시스템의 광학 설계는 낮은 수준의 빛이 방출된다는 점을 고려하여 필수적 사항인 집광을 극대화하기 위해 고도로 전문화되어 있습니다.
최적화된 광경로
물체에서 카메라까지의 광경로는 가능한 한 많은 빛이 CCD 칩에 도달할 수 있도록 직선이며 거리가 짧습니다. 또한 빛을 흡수하여 신호를 더욱 감소시키는 추가 반사경, 필터 또는 렌즈가 필요하지 않습니다. 또한 튜브 렌즈는 기존의 현미경 광학에 비해 극도로 높은 개구수(NA)로 설계되어 기존 현미경 광학에 비해 감도가 크게 향상되었습니다. 결과적으로 LV200은 기존 시스템보다 몇 배 더 높은 신호 출력을 생성하므로 기존 CCD 또는 EM-CCD 카메라와 함께 사용할 수 있습니다. LV200은 0.8배에서 20배까지 다양한 배율을 사용할 수 있어 큰 뇌 섹션에서 개별 세포까지 표본을 선명하게 이미지화할 수 있습니다.

고해상도 이미징
이러한 고유의 광학적 특성은 이전에는 발광 이미징으로 불가능했던 정교한 단일 세포 해상도를 보장합니다. 현재 사용 가능한 발광 프로브 수와 함께 이러한 개선 사항들은 현미경 이미징의 수준을 한층 더 끌어올릴 것을 보장합니다. 이러한 특성은 우수한 공간 해상도가 가능하여 신호가 많은 영역 근처의 약한 신호를 매우 쉽게 구별할 수 있는데, 이는 분광계에서는 불가능합니다.
일반 실험실 환경에서의 사용
LV200의 광밀폐 인클로저는 외부 빛으로부터 표본과 광학 장치를 보호하고 실험실의 주변 조명 아래에서 현미경을 사용할 수 있게 해줍니다. 매우 긴 노출 시간이 필요한 응용 분야 또는 표본의 경우 현미경을 조도가 낮은 방으로 옮겨야 할 수 있습니다.
현재의 이미징 기능 확장
발광 탐지에 최적화된 광학 부품을 갖춘 LV200은 광범위한 연구의 요건에 부합하도록 설계되었습니다. 여기 및 방출 필터 휠이 통합되어 있어 이중 색 발광과 투과광 형광 이미징이 가능합니다. 표준 명시야 조명 및 위상차 삽입물을 사용하면 발광 탐지로 전환하기 전에 표본의 목표 영역을 쉽게 찾을 수 있습니다. 따라서 명시야 이미지에서 발광 및 형광 오버레이를 생성할 수도 있으므로 이전에는 불가능했던 국소화 및 공동 국소화 기능이 가능합니다.


배양
이제 시스템이 장시간 이미징이 가능해짐에 따라 이미징 실험의 전체 시간 동안 표본을 스테이지에 그대로 둘 수 있는 것이 중요합니다. LV200은 표본이 매우 정확한 환경 챔버에 배치될 수 있도록 설계되었으며, 스테이지, 배양 챔버, 상단 덮개 및 대물 렌즈에 대해 독립적 온도 제어 기능을 갖추고 있습니다. 또한 정적 습도를 유지하기 위해 저수소를 사용하며, 이산화탄소 유량 조절을 통해 pH 안정성을 확보할 수 있습니다. 이러한 환경 제어를 통해 현미경과 배양기 간에 표본을 이동시킬 필요 없이 며칠 또는 심지어 몇 주에 걸쳐 지속적으로 표본을 모니터링 할 수 있습니다.
사양
빛이 세지 않는 어두운 상자
수동 대물렌즈 초점
전동 XY 스테이지:
표준 25mm 광학 필터를 위한 세 가지 위치의 전동 여기 필터 휠
표준 25mm 광학 필터를 위한 여섯 가지 위치의 전동 방출 필터 휠
도광체에 결합된 투과 명시야용 콘덴서
카메라용 C 마운트
발광 이미징에 최적화된 튜브 렌즈, 0.2배율
제어기, 스테이지 히터, 상단 덮개 히터를 포함하는 35mm 접시용 이중 챔버형 배양기
본체 히터, 대물렌즈 히터, 5% 이산화탄소 및 95% 공기용 유량계
응용 분야 및 요구되는 감도에 따라 냉각된 CCD 카메라, EM-CCD 카메라 또는 심층 냉각된 저속 스캔
CCD 카메라를 사용할 수 있습니다. (카메라/소프트웨어 호환성에 대해 문의하십시오.)
본체 850 VA
제어기 840 VA
추천 대물렌즈
응용분야
GL3 루시페레이스를 이용한 Hela 세포
NIH/3T3 세포

쥐 NIH3T3 섬유아세포

루시페레이즈, GFP 및 명시야

HeLa 세포

CHO 세포

양측 SCN

LUC 루시페레이스

LUC 루시페레이스
